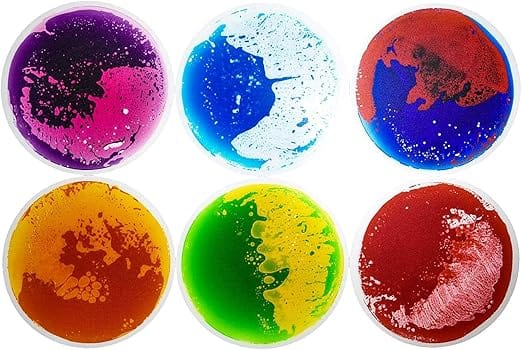

Family Owned Business
Over 20,000 happy families have trusted Sensory Assist to provide the quality and care their children need for sensory support
Customer Love
Real Feedback from Real Customers
Our Promise
Experience Unmatched Sensory Support with Sensory Assist
Tailored for All Ages
We offer a range of sizes and colours to suit everyone, from children to adults, ensuring a perfect fit for all.
Designed with Care
Our products are crafted from premium materials, ensuring durability and comfort. Designed with users in mind to minimise sensory disruptions.
Expert-Driven Solutions
Backed by years of experience, our team is dedicated to providing the highest quality sensory tools, ensuring you get the best support.
THE SENSORY ASSIST DIFFERENCE
Why Sensory Assist is the Smart Choice for Your Family
Discover why Sensory Assist stands out in a crowded market. We put quality, care, and community first, so you don’t have to compromise.


- Top-tier Quality
- Fair pricing
- NDIS Registered
- Parent-to-parent advice
- Commitment to giving back
- Fast, reliable shipping
- Customer-first service

- Inconsistent quality
- High markups
- Limited NDIS products
- Impersonal service
- Minimal community involvement
- Slow shipping
- Poor customer support
TOP PICKS
Discover Our Most Loved Sensory Tools